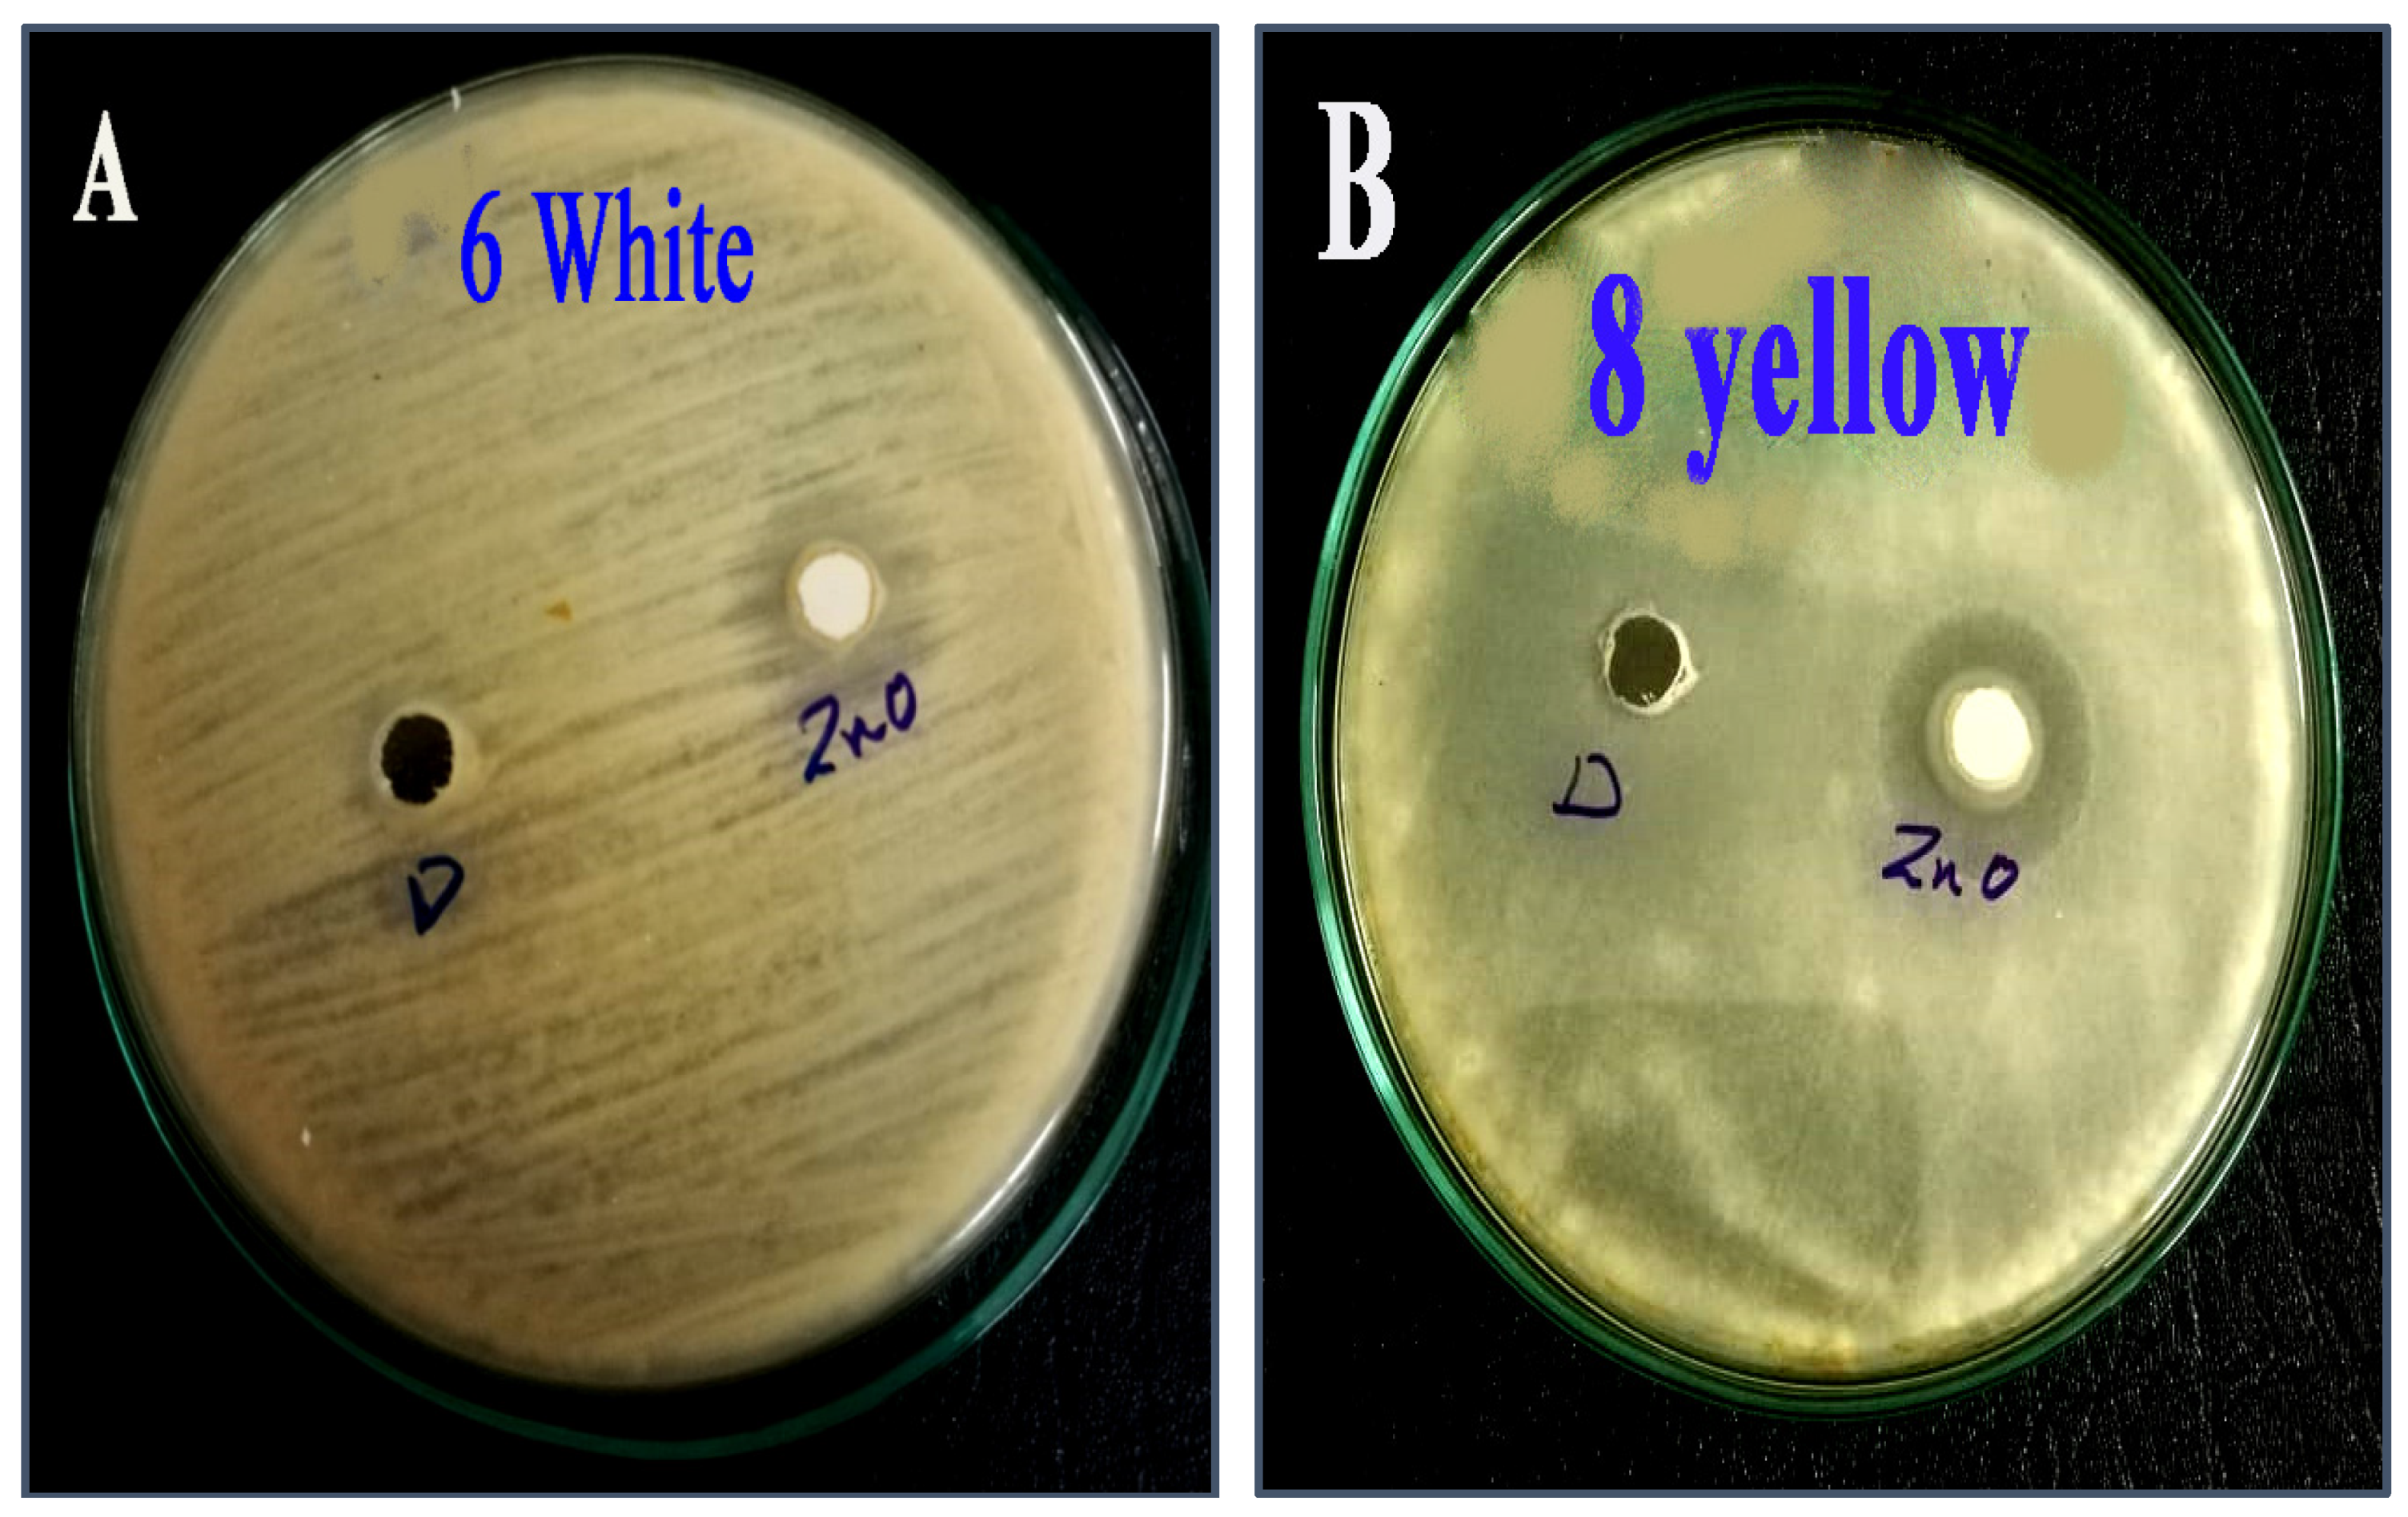
Molecules 28 00711 g008

Fungicidal Activity of Zinc Oxide Nanoparticles against Azole-Resistant Aspergillus flavus Isolated from Yellow and White Maize
Abstract
:1. Introduction
2. Results
2.1. Isolation and Identification of Azole-Resistant A. flavus
2.2. Characterization of Zinc Oxide Nanoparticle
2.3. The Susceptibility of Aspergillus flavus Isolates against Antifungal Agents
2.4. The Susceptibility of Aspergillus flavus Isolates against Zinc Oxide Nanoparticles
3. Discussion
4. Material and Methods
4.1. Sampling, Isolation, and Identification of Aspergillus flavus
4.2. Synthesis of Zinc Oxide Nanoparticles Using Chlorella vulgaris
4.3. Characterization of Zinc Oxide Nanoparticles
4.4. Antifungal Disk Diffusion Method
4.5. The Susceptibility of Aspergillus flavus Isolates
4.6. Preparation of Fungal Inoculums
4.7. The Antifungal Activity of Zinc Oxide Nanoparticle against Azole-Resistant A. flavus Isolates
4.7.1. Antifungal Disk Diffusion Method
4.7.2. Minimum Inhibitory Concentration (MIC)
5. Conclusions
Author Contributions
Funding
Institutional Review Board Statement
Informed Consent Statement
Data Availability Statement
Conflicts of Interest
Sample Availability
References
- Savary, S.; Willocquet, L.; Pethybridge, S.J.; Esker, P.; McRoberts, N.; Nelson, A. The Global Burden of Pathogens and Pests on Major Food Crops. Nat. Ecol. Evol. 2019, 3, 430–439. [Google Scholar] [CrossRef] [PubMed]
- Jørgensen, K.M.; Helleberg, M.; Hare, R.K.; Jørgensen, L.N.; Arendrup, M.C. Dissection of the Activity of Agricultural Fungicides against Clinical Aspergillus Isolates with and without Environmentally and Medically Induced Azole Resistant. J. Fungi 2021, 7, 205. [Google Scholar] [CrossRef]
- Nicolopoulou-Stamati, P.; Maipas, S.; Kotampasi, C.; Stamatis, P.; Hens, L. Chemical Pesticides and Human Health: The Urgent Need for a New Concept in Agriculture. Front. Public Health 2016, 4, 148. [Google Scholar] [CrossRef] [PubMed] [Green Version]
- Horn, B.W.; Moore, G.G.; Carbone, I. Sexual reproduction in Aspergillus flavus. Mycologia 2009, 101, 423–429. [Google Scholar] [CrossRef] [Green Version]
- Fountain, J.C.; Scully, B.T.; Ni, X.; Kemerait, R.C.; Lee, R.D.; Chen, Z.-Y.; Guo, B. Environmental influences on maize-Aspergillus flavus interactions and aflatoxin production. Front. Microbiol. 2014, 5, 40. [Google Scholar] [CrossRef] [PubMed] [Green Version]
- Hassan, A.; Elebeedy, D.; Matar, E.R.; Elsayed, A.F.M.; El Maksoud, A.I.A. Investigation of Angiogenesis and Wound Healing Potential Mechanisms of Zinc Oxide Nanorods. Front. Pharmacol. 2021, 12, 661217. [Google Scholar] [CrossRef]
- Sharaf, E.M.; Hassan, A.; AL-Salmi, F.A.; Albalwe, F.M.; Albalawi, H.M.R.; Darwish, D.B.; Fayad, E. Synergistic antibacterial activity of compact silver/magnetite core-shell nanoparticles core shell against Gram-negative foodborne pathogens. Front. Microbiol. 2022, 13, 929491. [Google Scholar] [CrossRef]
- Hassan, A.; Al-Salmi, F.A.; Abuamara, T.M.M.; Matar, E.R.; Amer, M.E.; Fayed, E.M.M.; Hablas, M.G.A.; Mohammed, T.S.; Ali, H.E.; El-Fattah, F.M.A.; et al. Ultrastructural analysis of zinc oxide nanospheres enhances anti-tumor efficacy against Hepatoma. Front. Oncol. 2022, 12, 933750. [Google Scholar] [CrossRef]
- Bitar, D.; Lortholary, O.; Le Strat, Y.; Nicolau, J.; Coignard, B.; Tattevin, P.; Che, D.; Dromer, F. Population-Based Analysis of Invasive Fungal Infections, France, 2001–2010. Emerg. Infect. Dis. 2014, 20, 1163–1169. [Google Scholar] [CrossRef]
- Le Pape, P.; Lavergne, R.-A.; Morio, F.; Alvarez-Moreno, C. Multiple fungicide-driven alterations in azoleresistant Aspergillus fumigatus, Colombia, 2015. Emerg. Infect Dis. 2016, 22, 156. [Google Scholar] [CrossRef] [PubMed]
- Alvarez-Moreno, C.; Lavergne, R.-A.; Hagen, F.; Morio, F.; Meis, J.F.; Le Pape, P. Fungicide-driven alterations in azole-resistant Aspergillus fumigatus are related to vegetable crops in Colombia, South America. Mycologia 2019, 111, 217–224. [Google Scholar] [CrossRef] [PubMed]
- Alvarez-Moreno, C.; Lavergne, R.-A.; Hagen, F.; Morio, F.; Meis, J.F.; Le Pape, P. Azole-resistant Aspergillus fumigatus harboring TR34/L98H, TR46/Y121F/T289A and TR53 mutations related to flower fields in Colombia. Sci. Rep. 2017, 7, 45631. [Google Scholar] [CrossRef] [Green Version]
- Colon, G.; Ward, B.C.; Webster, T.J. Increased osteoblast and decreased Staphylococcus epidermidis functions on nanophase ZnO and TiO2. J. Biomed. Mater. Res. Part A 2006, 78A, 595–604. [Google Scholar] [CrossRef] [PubMed]
- Bondarenko, O.; Juganson, K.; Ivask, A.; Kasemets, K.; Mortimer, M.; Kahru, A. Toxicity of Ag, CuO and ZnO nanoparticles to selected environmentally relevant test organisms and mammalian cells in vitro: A critical review. Arch. Toxicol. 2013, 87, 1181–1200. [Google Scholar] [CrossRef] [PubMed] [Green Version]
- Padmavathy, N.; Vijayaraghavan, R. Enhanced bioactivity of ZnO nanoparticles-antimicrobial study. Sci. Technol. Adv. Mater. 2008, 9, 035004. [Google Scholar] [CrossRef]
- Sharma, D.; Rajput, J.K.; Kaith, B.S.; Kaur, M.; Sharma, S. Synthesis of ZnO nanoparticles and study of their antibacterial and antifungal properties. Thin Solid Film. 2010, 519, 1224–1229. [Google Scholar] [CrossRef]
- Xu, X.; Chen, D.; Yi, Z.; Jiang, M.; Wang, L.; Zhou, Z.; Fan, X.; Wang, Y.; Hui, D. 372 Antimicrobial mechanism based on H2O2 generation at oxygen vacancies in ZnOcrystals. Langmuir 2013, 29, 5573–5580. [Google Scholar] [CrossRef]
- Moritz, M.; Geszke-Moritz, M. The newestachievements in synthesis, immobilization and practical applications of antibacterial nanoparticles. Chem. Eng. J. 2013, 228, 596–613. [Google Scholar] [CrossRef]
- Van Dong, P.; Ha, C.H.; Binh, L.T.; Kasbohm, J. Chemical synthesis and antibacterial activity of novel-shaped silver nanoparticles. Int. Nano Lett. 2012, 2, 9. [Google Scholar] [CrossRef] [Green Version]
- Khan, M.F.; Hameedullah, M.; Akhter, H.; Ansari; Ahmad, E.; Lohani, M.; Khan, R.H.; Alam, M.M.; Khan, W.; Husain, F.M.; et al. Flower-shaped ZnO nanoparticles synthesized by a novel approach at near-room temperatures with antibacterial and antifungal properties. Int. J. Nanomed. 2014, 9, 853–864. [Google Scholar] [CrossRef]
- Zhang, J.; Liu, Y.; Li, Q.; Zhang, X.; Shang, J.K. Antifungal Activity and Mechanism of Palladium-Modified Nitrogen-Doped Titanium Oxide Photocatalyst on Agricultural Pathogenic Fungi Fusarium graminearum. ACS Appl. Mater. Interfaces 2013, 5, 10953–10959. [Google Scholar] [CrossRef]
- Decelis, S.; Sardella, D.; Triganza, T.; Brincat, J.-P.; Gatt, R.; Valdramidis, V.P. Assessing the anti-fungal efficiency of filters coated with zinc oxide nanoparticles. R. Soc. Open Sci. 2017, 4, 161032. [Google Scholar] [CrossRef] [Green Version]
- Li, Y.; Zhang, W.; Niu, J.; Chen, Y. Mechanism of photogenerated reactive oxygen species and correlation with the antibacterial properties of engineered metal-oxide nanoparticles. ACS Nano 2012, 6, 5164–5173. [Google Scholar] [CrossRef]
- Xu, J.; Li, Z.; Xu, P.; Xiao, L.; Yang, Z. Nanosized copper oxide induces apoptosis through oxidative stress in podocytes. Arch. Toxicol. 2013, 87, 1067–1073. [Google Scholar] [CrossRef] [PubMed]
- Pitt, J.; Hocking, A. Fungi and Food Spoilage; Blackie Academic and Professional; Springer: London, UK, 2009. [Google Scholar] [CrossRef]
- Harborne, J.; Williams, C. Advances in flavonoid research since 1992. Phytochemistry 2000, 55, 481–504. [Google Scholar] [CrossRef]
- Esmadi, F.; Khabour, O.F.; Albarqawi, A.I.; Ababneh, M.; Al-Talib, M. Synthesis and Characterization of Some Transition Metal Complexes of Thiocarbohydrazone Schiff Bases. Jordan J. Chem. 2013, 8, 31–43. [Google Scholar] [CrossRef]
- Alhazmi, N.M. Fungicidal Activity of Silver and Silica Nanoparticles against Aspergillus sydowii Isolated from the Soil in Western Saudi Arabia. Microorganisms 2023, 11, 86. [Google Scholar] [CrossRef]
- CLSI. Reference Method for Broth Dilution Antifungal Susceptibility Testing of Filamentous Fungi; Approved Standard CLSI Document M38-A2; Clinical and Laboratory Standards Institute: Wayne, PA, USA, 2008. [Google Scholar]
- Cuenca-Estrella, M.; Moore, C.; Barchiesi, F.; Bille, J.; Chryssanthou, E.; Denning, D.; Donnelly, J.; Dromer, F.; Dupont, B.; Rex, J.; et al. Multicenter evaluation of the reproducibility of the proposed antifungal susceptibility testing method for fermentative yeasts of the Antifungal Susceptibility Testing Subcommittee of the European Committee on Antimicrobial Susceptibility Testing (AFST-EUCAST). Clin. Microbiol. Infect. 2003, 9, 467–474. [Google Scholar]
- Subcommittee on Antifungal Susceptibility Testing (AFST) of the ESCMID European Committee for Antimicrobial Susceptibility Testing (EUCAST). Method for the determination of Broth dilution MICs of antifungal agents for fermentative yeasts. Clin. Microbiol. Infect. Dis. 2008, 14, 398–405. [Google Scholar] [CrossRef]

| The Source of Azole-Resistant A. flavus Isolates | No. of Isolates |
|---|---|
| White corn | 12 |
| Yellow corn | 4 |
| Tested M.O. | Terbinfine | Voricazole | Ketoconazole | Fluconazole | Amphotericin | Nystatin |
|---|---|---|---|---|---|---|
| A.flavus (white corn) | 40 ± 0.9 | 20 ± 0.2 | 12 ± 0.4 | NA | NA | NA |
| A.flavus (yellow corn) | 41 ± 0.5 | 13 ± 0.6 | 11 ± 0.1 | NA | 7 ± 0.2 | NA |
| Tested Micro-Organisms | Inhibition Zone (mm) | MIC (mg/mL) |
|---|---|---|
| A. flavus (white corn) | 13 nm | 50 ± 2.3 |
| A. flavus (yellow corn) | 14 nm | 25 ± 1.6 |
| Antifungal Disc | Concentration |
|---|---|
| Terbinfine | 100 mg/mL |
| Fluconazole | 25 mg/mL |
| Ketoconazole | 30 mg/mL |
| Voricazole | 1 mg/mL |
| Amphotericin | 100 mg/mL |
| Nystatin | 100 mg/mL |
Disclaimer/Publisher’s Note: The statements, opinions and data contained in all publications are solely those of the individual author(s) and contributor(s) and not of MDPI and/or the editor(s). MDPI and/or the editor(s) disclaim responsibility for any injury to people or property resulting from any ideas, methods, instructions or products referred to in the content. |
© 2023 by the authors. Licensee MDPI, Basel, Switzerland. This article is an open access article distributed under the terms and conditions of the Creative Commons Attribution (CC BY) license (https://creativecommons.org/licenses/by/4.0/).
Share and Cite
Alhazmi, N.M.; Sharaf, E.M. Fungicidal Activity of Zinc Oxide Nanoparticles against Azole-Resistant Aspergillus flavus Isolated from Yellow and White Maize. Molecules 2023, 28, 711. https://doi.org/10.3390/molecules28020711
Alhazmi NM, Sharaf EM. Fungicidal Activity of Zinc Oxide Nanoparticles against Azole-Resistant Aspergillus flavus Isolated from Yellow and White Maize. Molecules. 2023; 28(2):711. https://doi.org/10.3390/molecules28020711
Chicago/Turabian StyleAlhazmi, Nuha M., and Eman M. Sharaf. 2023. "Fungicidal Activity of Zinc Oxide Nanoparticles against Azole-Resistant Aspergillus flavus Isolated from Yellow and White Maize" Molecules 28, no. 2: 711. https://doi.org/10.3390/molecules28020711
APA StyleAlhazmi, N. M., & Sharaf, E. M. (2023). Fungicidal Activity of Zinc Oxide Nanoparticles against Azole-Resistant Aspergillus flavus Isolated from Yellow and White Maize. Molecules, 28(2), 711. https://doi.org/10.3390/molecules28020711








